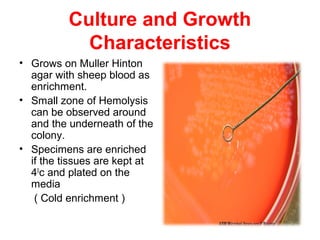
Culture and Growth
Characteristics
• Grows on Muller Hinton
agar with sheep blood as
enrichment.
• Small zone of Hemolysis
can be observed around
and the underneath of the
colony.
• Specimens are enriched
if the tissues are kept at
40
c and plated on the
media
( Cold enrichment )
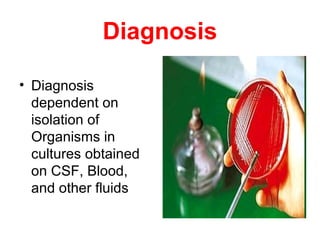
Diagnosis
• Diagnosis
dependent on
isolation of
Organisms in
cultures obtained
on CSF, Blood,
and other fluids

This document discusses Listeria monocytogenes, the bacterium that causes listeriosis. It affects pregnant women, newborns, elderly and immunocompromised individuals. The disease is contracted by eating contaminated food and has flu-like symptoms initially. It can later cause meningitis in newborns. Treatment involves antibiotics like ampicillin. Pregnant women are advised to avoid foods like hot dogs, soft cheeses and deli meats to prevent listeriosis.